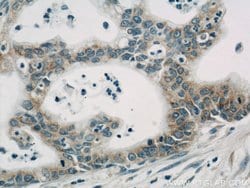
Cyclophilin B Mouse anti-Human, Mouse, Rat, Clone: 8H4F1, Proteintech 150

missing translation for 'onlineSavingsMsg'
Learn More
Learn More
Cyclophilin B Mouse anti-Human, Mouse, Rat, Clone: 8H4F1, Proteintech
Mouse Monoclonal Antibody
Brand: Proteintech 66047-1-IG-150UL
This item is not returnable.
View return policy
Description
Immunophilins are a family of soluble cytosolic receptors capable of binding to one of two major immunosuppressant agents - cyclosporin A (CsA) or FK506. Proteins which bind FK506 are termed FK506 Binding Proteins (FKBP′s) and those which bind cyclosporin A are called cyclophilins (CyP). Both CyP:CsA and FKBP:FK506 complexes have been shown to inhibit calcineurin, a calcium and calmodulin dependent protein phosphatase which has been implicated as an important signaling enzyme in T-cell activation. Thus, providing a possible mechanism of immunosuppression by CsA and FK506. Immunophilins function as peptidyl prolyl cis-trans-isomerases (PPIase) whose activity is inhibited by their respective immunosuppressant compounds. As PPIase′s, immunophilins accelerate folding of some proteins both in vivo and in vitro by catalyzing slow steps in the initial folding and rearrangement of proline containing proteins.Specifications
| Cyclophilin B | |
| Monoclonal | |
| 1 mg/mL | |
| PBS with 50% glycerol and 0.02% sodium azide; pH 7.3 | |
| P23284, P24368, P24369 | |
| Ppib | |
| Cyclophilin B Fusion Protein Ag17957 | |
| 150 μL | |
| Primary | |
| Human, Mouse, Rat | |
| Antibody | |
| IgG2a |
| Immunocytochemistry, Immunofluorescence, Immunohistochemistry (Paraffin), Western Blot | |
| 8H4F1 | |
| Unconjugated | |
| PPIB | |
| Cyclophilin B, CYP S1, CYPB, PPIase B, Rotamase B, S cyclophilin, SCYLP | |
| Mouse | |
| Protein A | |
| RUO | |
| 19035, 5479, 64367 | |
| -20°C | |
| Liquid |
Product Content Correction
Your input is important to us. Please complete this form to provide feedback related to the content on this product.
Product Title
Spot an opportunity for improvement?Share a Content Correction